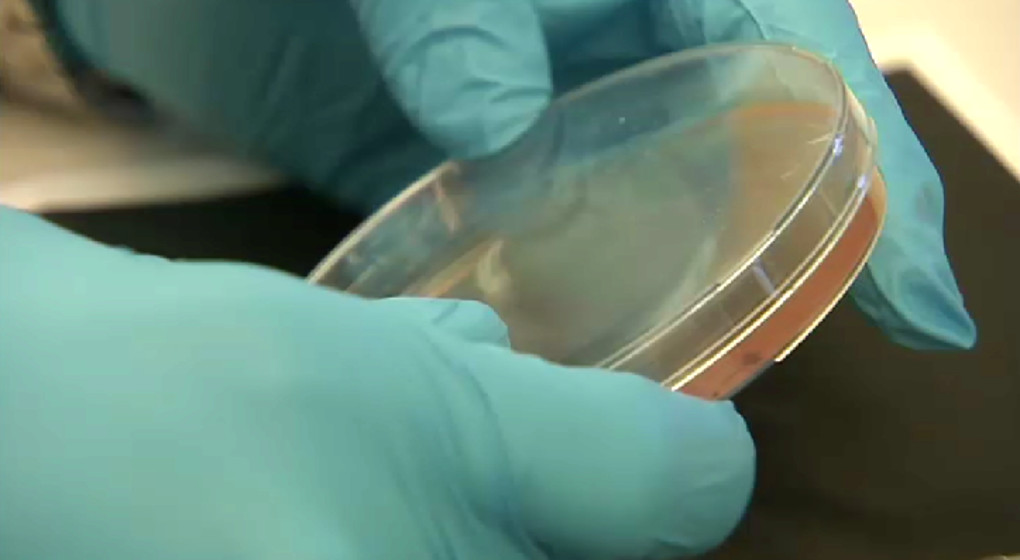

Le parquet de Bruxelles ouvre une enquête judiciaire sur les contaminations à la bactérie dans des maisons de repos
Le parquet de Bruxelles a ouvert une enquête judiciaire concernant les contaminations à la bactérie STEC survenues dans des maisons de repos belges en août, a indiqué vendredi le ministère public, confirmant une information de VRT Nieuws.
Fin août, des contaminations par la bactérie Escherichia coli productrice de shigatoxines (STEC) avaient touché des résidents de onze maisons de repos en Flandre, Wallonie et à Bruxelles. Ces contaminations avaient causé neuf décès et provoqué des symptômes chez plus de 70 personnes.
L’enquête menée par l’Afsca, Sciensano, le Centre national de référence et les autorités sanitaires régionales a identifié la consommation de haché de bœuf cru comme cause la plus probable de la contamination. Dans les établissements concernés, de la viande issue d’un même lot avait été servie. Au total, plus de 70 échantillons alimentaires de produits de la chaîne d’approvisionnement ont été analysés.
Cependant, l’absence d’échantillons disponibles du lot de viande incriminé empêche de confirmer avec certitude la source de contamination par analyses de laboratoire.
Belga